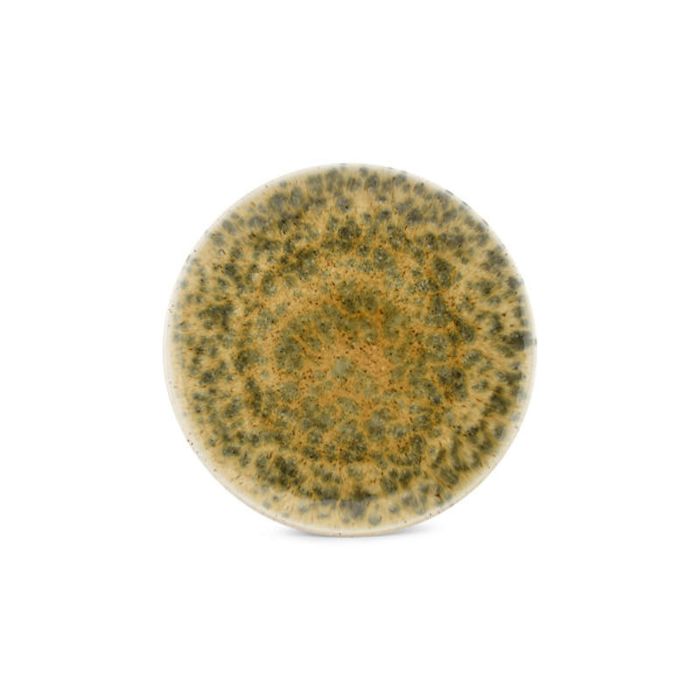

Plate 25cm greenbrown Resto
SKU: 743001
- Tailored for hospitality
- Quality, style and value in one
- Built for daily use
SKU | 743001 |
---|---|
Brand | Bonbistro |
Collection | Resto |
Product type | Plate |
New | Jan 3, 2023 |
Main color | Brown |
Colors | Brown, Green |
Main material | Porcelain |
Materials | Porcelain |
Finish | Reactive Glazing |
Shape | Round |
Commercial dimensions | 25cm |
Diameter | 25 |
Length (cm) | 25 |
Width (cm) | 25 |
Height (cm) | 2.2 |
Weight | 0,61 |
Dishwasher safe | Yes |
Dubbelwalled | No |
Food safe | Yes |
Giftbox | No |
Handmade features | No |
Microwave oven safe | Yes |
Oven safe | No |
From recycled material | No |
Qty Increments | 6 |
Barcode: 25410595752090
Width: 0.27 m
Height: 0.1 m
Length: 0.27 m
Weight: 3.66 kg
Quantity: 6
Barcode: 15410595752093
Width: 0.21 m
Height: 0.29 m
Length: 0.285 m
Weight: 7.32 kg
Quantity: 12
Barcode: 35410595752097
Width: 0.8 m
Height: 1.03 m
Length: 1.2 m
Weight: 307.44 kg
Quantity: 504

Plate 25cm greenbrown Resto